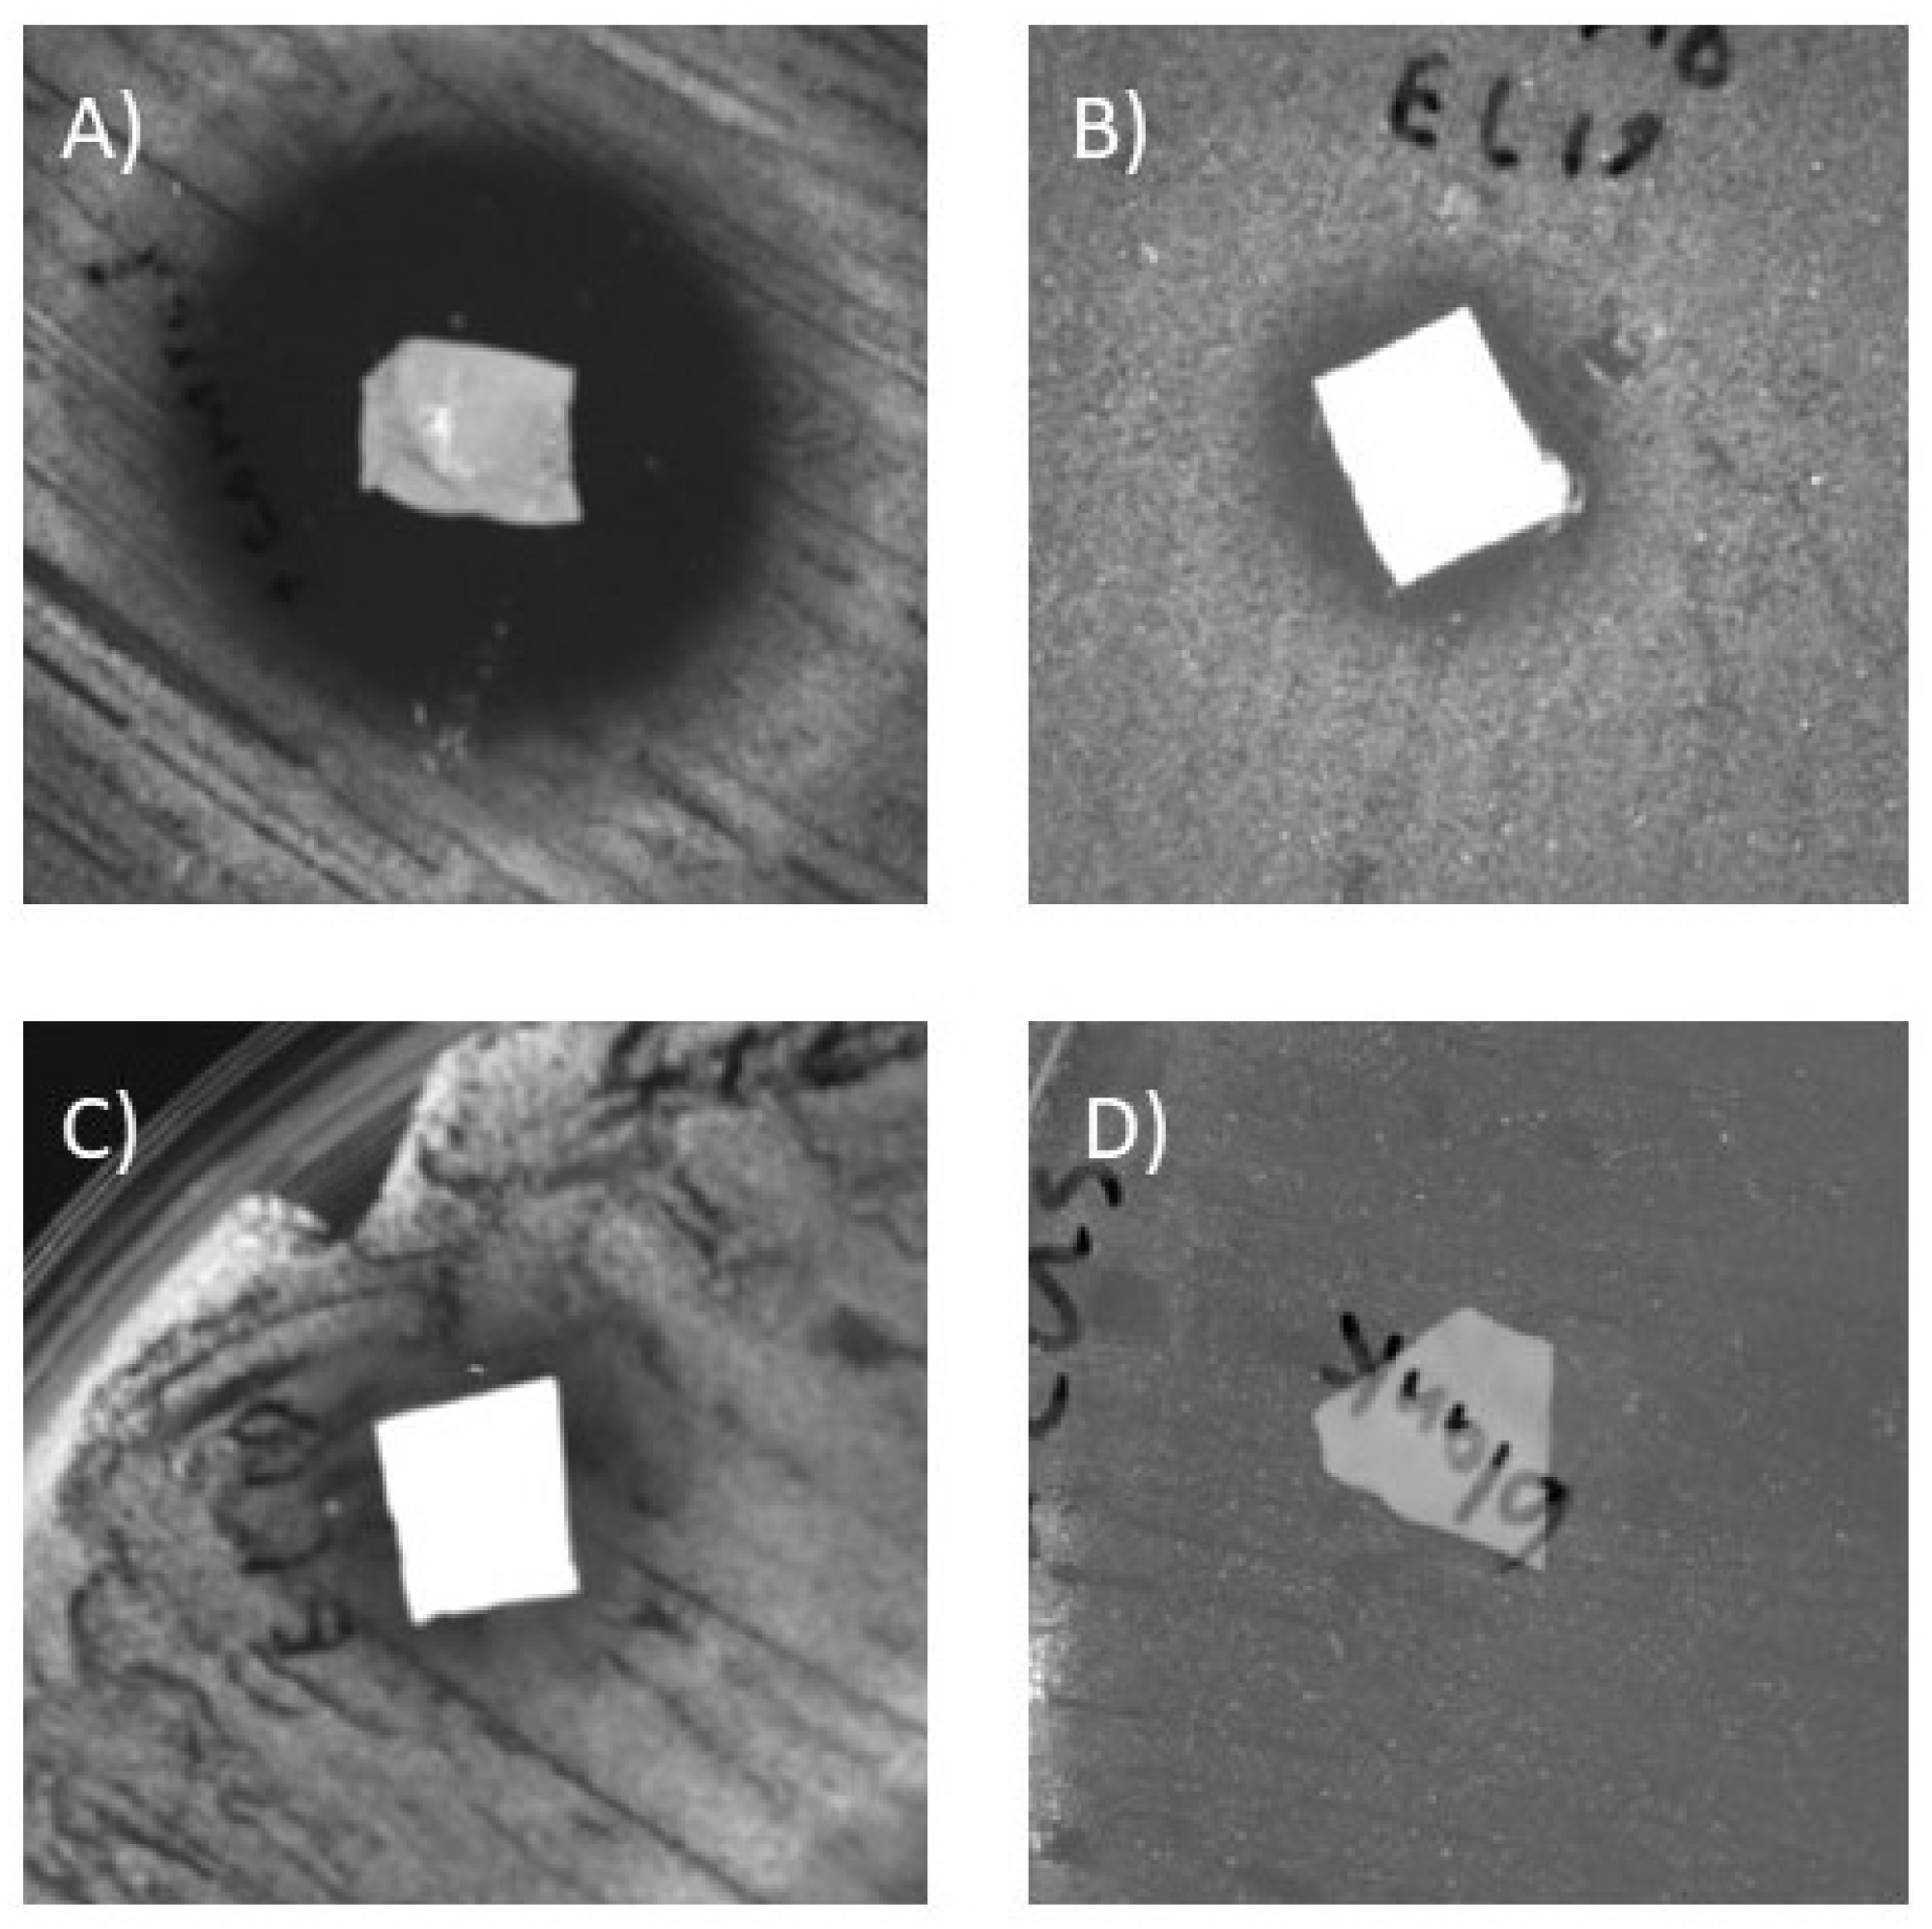
Preprints 91151 g004

1. Introduction
The human skin serves as a vital barrier, protecting us against the external environment factors and microbial invasions. When this protective barrier is damaged, it allows microorganisms to penetrate the surface, potentially leading to infections. In severe cases, this can lead to life-threatening complications, such as the loss of essential body fluids and nutrients. This issue emphasizes the global challenge of wound care, particularly in the context of chronic wounds that are not going through the natural healing process [
1]. The data has confirmed that more than 305 million people suffer from wounds worldwide and the annual cost of chronic wound care is expected to reach
$80 billion by 2024, globally [
2].
The importance of this issue has sparked a growing enthusiasm among researchers to investigate various wound dressing options. These dressings are designed to absorb exudate, combat the infection, relieve the pain, promote autolytic debridement, or even provide and maintain a moist environment at the wound surface. However, no single wound dressing fulfills all these objectives comprehensively. The selection of wound dressing depends on factors such as patient’s health status, wound characteristics (type, location, depth), amount of exudate, adhesion properties, and economic considerations [
3].
Hydrogels, foams, dermal patches, films, nanoparticles, hydrocolloids, nanofibers, emulgels and membranes represent the primary categories of wound dressings. Among these, electrospun fibers and nanofibers stand out as a particularly noteworthy type of wound dressings. Their notable attributes, including high surface area, porosity, and drug-loading potential, have motivated extensive research and development efforts [
4].
Using an effective wound dressing is expected to enhance the healing process and reduce the likelihood of bacterial infections. The management of bacterial growth and wound infections represents a great challenge in wound healing process. In this context, wound dressing materials are often customized with antibacterial agents to reduce these risks during the healing process [
5]. However, it is noteworthy that the emergence of AMR has introduced significant obstacles to the use of conventional antimicrobial agents in wound dressings. AMR represents one of the most significant contemporary challenges in global public health. Lack of new antibiotics and antibacterial agents, coupled with the widespread distribution and misuse of existing antibacterial compounds, has led to a surge in antimicrobial resistance, which raises concerns about a potential return to the pre-antibiotic era with infections containing multiple-resistant pathogens affecting ten million lives in the world by 2050 [
6,
7].
The data confirms the presence of
Staphylococcus aureus (
S. aureus) as the most common Gram-positive bacteria on wound surfaces with the share of 75.9 % [
8]. MRSA is a substantial contributor to healthcare- and community-associated infections on a global scale. In healthcare settings alone, 150,000 patients annually within the European Union are estimated to be impacted by MRSA infections. These infections have given rise to additional in-hospital costs of EUR 380 million for healthcare systems in the Europe. Besides, the data on bloodstream infections confirms the presence of up to 50% MRSA among
S. aureus infections [
9].
MRSA exhibits resistance to beta-lactam antibiotics such as penicillin, methicillin, and oxacillin. As some of the important conventional antibiotics are not working against MRSA, thus the treatment is normally furthered using alternatives such as glycopeptides, vancomycin and teicoplanin. It is worth noting that MRSA has been documented to exhibit resistance against some of these antibiotics. Furthermore, the use of effective antibiotics such as mupirocin and clindamycin, is restricted due to the risk of resistance development. Consequently, there is an ongoing demand for alternative antibacterial agents for the treatment and prevention of MRSA infections on wound surfaces [
10].
In recent years, endophytes as one of the most promising alternatives have gained a lot of attention. These sources, as a recognised source of secondary metabolites, show a great potential in various medicinal and agricultural applications [
11,
12]. However, considering that there are numerous plants and endophytes growing in each ecosystem, screening them all would be impossible. Moreover, there are limited information about some specific plants and endophytes. Australian native plants are not an exception in this case. There are a lot of promising Australian plant sources that can produce antibacterial compounds through their secondary metabolites. In order to investigate these groups of plants, a focused approach is needed for plant selection. The rich ethnomedicinal history of some of these plants through thousands of years of utilization among indigenous societies in Australia has created a valuable pool of these promising sources.
Indigenous Australians have historically held a wealth of knowledge about potentially medicinal Australian native plants. Although much of this knowledge was eroded during European colonization, several studies now validate the capacity of these plants to generate bioactive compounds [
13]. Some of these plant species are,
Eremophila longifolia (snakevine), which was used to treat cold and bruises by Australian aboriginal communities [
14],
Callitris preissii (native pine tree),
Eucalyptus camaldulensis (Red gum),
Eucalyptus microcarpa (Grey Box),
Pittosporum phylliraeoides (native apricot tree) [
15], and
Gossypium species [
16].
Numerous research papers have centred on investigating the antibacterial potential of endophytes in wound dressings. A notable example is the work of Firoozbahr et al., who shed light on the capacity of endophytic fungi to act as effective antibacterial agents in wound dressings [
3].
Furthermore, in a study conducted by Ingrey et al., different plants from Dharawal country within the Gamay National Park—an Australian indigenous community—were selected as a source for endophytic fungi. Out of the 48 endophyte isolates examined, 19 tested positive for the presence of polyketide synthase or non-ribosomal peptide synthetase, as identified through PCR using degenerate primers. The findings indicate that Australian bush medicines encompass a variety of microbial endophytes with notable biosynthetic capabilities. These microbial endophytes offer potential as antibacterial agents, highlighting their promising application in therapeutic contexts [
17].
The objective of this study was to investigate 32 endophytic fungi, previously isolated by our group from the leaves of 13 distinct species of Australian native plants, for their antibacterial and antibiofilm activities against S. aureus and MRSA species. Initially, EtOAc and aqueous extracts derived from the fungal culture broths were screened for their inhibitory and bactericidal effects. Next, each active isolate was identified through DNA sequencing, followed by an evaluation of their capacity to inhibit biofilm formation. Finally, the antibacterial activity of various concentrations of bioactive metabolites of the most active sample was incorporated into PCL nanofibers. These nanofibers were subsequently tested against S. aureus for their antibacterial activity to determine the presence of antimicrobial components.
2. Materials and Methods
2.1. Preparation of Fungal Extracts from Australian Native Plants
Leaves of 13 types of plants were obtained from a nursery in Mount Evelyn Victoria. These plants were Eremophila Longifolia (EL), Eremophila kalbarricarpet (EKC), Eremophila kalgoorlie (EK) Eremophila maculata salmon form (EMSF), Eremophila calorhabdos x denticulate (EC), Eremophila glabra subsp. carnosa (EGSC), Eremophila bignoniifolia (EB), Eremophila muelleriana (EMM), Eremophila glabra (EG), Eremophila nivea (EN), Eremophila glabra x nivea (EGXN), Eremophila racemose x maculate (ERXM), and Eremophila maculata silver emu bush (EMSEB).
For endophyte isolation, leaves from the selected plants were employed as the primary source. The protocol outlined by Strobel and Daisy [
18], and Zaferanloo et al. [
19], was followed. The isolation process commenced with sterilization using 70% ethanol within a laminar flow hood to prevent environmental contamination. Following the removal of outer tissues using a sterile scalpel blade, the leaves were cautiously placed on water agar plates. These plates were then incubated at 25°C for several days until the emergence of fungal mycelia was observed. To establish distinct cultures, hyphal tips were transferred onto fresh potato dextrose agar (PDA) plates. After an additional incubation period at 25°C for several days, various subcultures were examined and transferred onto new PDA plates to be confirmed as purified. Over a span of 5-7 days, the growth of endophytic colonies became visible, prompting multiple rounds of subculturing to achieve a state of pure culture.
In the next step, all the samples went through the solvent extraction process. In this method, after growing mycelia in PDB (incubation for 14 days at 28 °C), the fermentation broth was separated from the biomass using vacuum filtration through Whatman filter paper No. 1. After discarding the biomass, the filtrate was extracted using EtOAc as an organic solvent. In the final step, the solvent evaporated with the help of a rotary evaporator (BUCHI, Essen, Germany) setting at 45 °C and 0.22 millibar to reach the extracted secondary metabolites with a small amount of solvent. The solutions then were transferred to 1.5 mL microcentrifuge tubes, which placed in a vacuum concentrator (Christ, Osterode am Harz, Germany) at 40 °C to remove the remaining solvent. Finally, the extracted metabolites were dissolved in 1 to 1.5 mL of dimethyl sulfoxide (DMSO) and stored at -20 °C for further stages [
20].
In a separate batch, the aqueous extracts of each fermentation broth were prepared. Following the separation of the fermentation broth from the biomass, as explained in the previous paragraph, the filtrate was stored in -80 °C and then subjected to freeze-drying using a Telstar freeze-drier (Azbil group, Japan) for 4 days at -20 °C. Following the removal of the aqueous solvent, the remaining metabolites were dissolved in 5% DMSO and stored at -20 °C for further stages.
2.2. Bacterial Cultures
Extracts were tested against S. aureus ATCC25923, obtained from the Department of Chemistry and Biotechnology, Swinburne University of Technology, Melbourne, Australia. They were also tested against bacterial colonies of MRSA M180920 provided by Microbiology Department, Austin and Repatriation Medical Centre, Victoria, Australia. All bacteria were grown in Mueller-Hinton agar (MHA) plates overnight at 37°C. Then, Mueller-Hinton broth (MHB) was used to prepare liquid cultures from these plates.
2.3. Disc Diffusion Assay
The disc diffusion assay was furthered using the European Committee on Antimicrobial Susceptibility Testing (EUCAST) method [
21]. MHA plates were prepared using the manufacturer’s instruction. The media then autoclaved at 121°C for 15 mins and transferred into sterile 90mm petri dishes. Bacterial colonies were cultured overnight at 37 °C in MHB then diluted with fresh MHB to match the turbidity of a 0.5 McFarland standard, equivalent to 1.5 × 10
8 CFU/mL (Colony forming unit per millilitre) in the absorbance at 600 nm (OD
600=0.08-0.1). In a laminar flow biosafety cabinet, sterilized cotton swabs were dipped into the bacterial solution and swabbed over the surface of the agar plates in three directions to ensure complete and uniform coverage of the solution. In the next step, 6 mm sterilized paper discs were placed on the agar surface using sterile forceps. Then 10 µL of each sample (EtOAc and aqueous extracts in DMSO) as well as appropriate controls were loaded on each disk. Plates were incubated at 37 °C for 18-24 hrs and checked for inhibition zones.
2.4. Determination of MIC
The investigation for obtaining MIC was furthered using the broth microdilution method described by the EUCAST [
22]. In this test, a starting concentration of 40 mg/mL in DMSO was prepared for each sample. 100 μL of each extracted metabolite was added to the first well of separate rows in a round-bottomed 96-well microtiter plate, while 50 μL of sterile MHB was added to wells 2-12 of each row. Dilutions were performed serially by transforming 50 μL from well 1 to well 2 in the corresponding row, then 50 μL from well 2 to well 3, and so on until well 12. Then 50 μL from the last well was discarded. The bacterial inoculums were prepared by diluting an overnight culture at 37 °C in MHB into fresh MHB to match the turbidity of a 0.5 McFarland standard, equivalent to 1.5 × 10
8 CFU/ml. The bacterial solution then diluted to 1:20 by adding 2mL of the suspensions to 38 mL of sterile distilled water, which resulted in a concentration of approximately 5 × 10
5 CFU/mL in each well. In the next step, 40 μL of additional media were added to each well, followed by 10 μL of the abovementioned bacterial solution. After incubation for 24 hours at 37 °C, the results were obtained by visual inspection of the lowest dilution with no bacterial growth.
2.5. Determination of MBC
After testing the growth assay to assess the inhibition concentration of the samples in a 96-well plate, the MBC test was performed for the most active sample by transferring 20 µL of each well on nutrient agar plate and incubated overnight at 37 °C. The bacterial growth after a 24-hour time frame suggested the presence of the live bacteria in the solution. Thus, the lowest concentration with no bacterial growth was considered as the MBC.
2.6. Extraction of Fungal DNA
Followed by the bioactivity tests on each sample, the top four active samples were selected for identification. Fungal genomic DNA was extracted from the fungal culture that was previously prepared by growing in potato dextrose broth (PDB). Sanger sequencing was furthered using a Quick-DNATM Miniprep Kit (Zymo Research, Irvine, CA, USA) using a MPI FastPrep-24 Beater and Eppendorf mini spin plus tubes where necessary. The mixture was placed in a FastPrep-24 homogenizer (MP Biomedicals) for 120 seconds at 6.0 m/s for cell disruption. After running this step twice for ensuring successful cell lysis, each of the samples was centrifuged for 10 min at 14,000 g to remove cell debris. The rest of the process was conducted using manufacturer’s instructions.
DNA quality was subsequently validated using a Thermo Scientific NanoDrop One spectrophotometer, measuring within the range of 220-350 nm, and recording both DNA concentration (µg/mL) and the absorbance ratio of wavelengths 260/280 (A260/280). Following the confirmation of sample quality, the DNA samples were put through PCR. In 200 µL PCR tubes, 2 µL of extracted DNA sample, 1 µL magnesium chloride (MgCl_2), 1 µL of each primer, ITS1 (5′-TCC GTA GGT GAA CCT GCG G-3′) and ITS4 (5′-TCC TCC GCT TAT TGA TAT GC-3′), and 25 µL PlatinumTM SuperFiTM II Green PCR Master Mix (Thermo Fisher Scientific, MA, USA). By adding HPLC grade purified water, the final volume of each tube was adjusted to 50 µL. To amplify the target region, the tubes were placed into a thermocycler using a 1 denaturation cycle at 95 °C for 5 minutes, then 35 cycles of 95 °C for 30 seconds, followed by 59 °C for 45 seconds, and 72 °C for 60 seconds. For the final extension 1 cycle 72 °C for 7 minutes was used. For confirming the quality of the amplified bands, PCR products were analysed using a 2 % (w/v) agarose gel. After purification of the products using an ISOLATE II PCR and Gel Kit (Bioline, Eveleigh, Australia) using the manufacturer’s instructions, all the DNA samples were prepared using Australian Genome Research Facility (AGRF, Melbourne, Australia). Samples were then submitted to AGRF and the resulted sequencing data were analysed using the Basic Local Alignment Search Tool (BLAST) available on the NCBI GenBank database.
2.7. Antibiofilm Activity
The fungal extract exhibiting the highest activity was selected for evaluation of its antibiofilm efficacy against chosen bacterial strains. The experimental procedure assessed its capability to inhibit initial cell attachment and subsequent biofilm formation using the crystal violet (CV) staining method described by Stepanović et al. [
23], Jadhav et al. [
24], and Caruso et al. [
10].
To prepare bacterial inocula, each strain was initially cultured overnight at 37 °C in tryptic soy broth with glucose (TSBG) within sterile polystyrene tubes (SPL Life Sciences, Republic of Korea). The resultant bacterial cultures were then diluted with fresh TSBG to achieve a 0.5 McFarland standard. Subsequently, this solution was further diluted at a ratio of 1:100 in sterile TSBG. The most active sample was prepared in three concentrations of
× MIC,
× MIC, and
×MIC (adjusted with MIC in TSBG) as a stock solution of 50 × their final desired concentration in DMSO. Subsequently, 4 µL of each extract was added into individual wells of a 96-well polystyrene plate (SPL Life Sciences, Republic of Korea), followed by the addition of 196 µL of the diluted bacterial suspension. Proper positive and negative controls were prepared by utilizing 200 µL of bacterial suspension and 200 µL of sterile TSBG, respectively. The positive control represented 100% biofilm formation, while the negative control indicated 0% biofilm formation. Following a 24-hour incubation period at 37 °C, the culture medium was gently removed by pipetting, and the residual biofilm was subjected to two washes with sterile room temperature phosphate-buffered saline (PBS). Next, the biofilms were fixed by exposure to a 60 °C oven for 1 hour. Staining was accomplished by adding 190 µL of 0.02% CV to each well, followed by a 10-minute incubation at room temperature. After removing excess CV by pipetting, each well was rinsed with fresh PBS at room temperature and further washed under gently running distilled water to eliminate the extra stain. In the final step, 150 µL of 33% acetic acid was added to each well and allowed to remain at room temperature until the stain dissolved. The absorbance of each well then was measured at 595 nm using microplate reader ((POLARstar Omega, BMG Labtech, Ortenberg, Germany). All measurements were conducted in triplicates, and the data was reported as the average of these results. The calculation of biofilm formation inhibition was performed in relation to the controls using the following equation:
2.8. Fiber Production
The electrospinning process was conducted using NS1 Inovenso Electrospinner (Inovenso, Istanbul, Turkey) based on Venugopal et al. [415] method with some modifications. PCL, with an average molecular weight of 80,000 g/mole (Sigma-Aldrich, MO, USA) was dissolved in methanol/chloroform 1:3 under the room temperature and a mechanical agitation using a magnet stirrer in order to reach a homogenous clear viscous solution (15 wt %). Three different concentrations of the most active EtOAc or aqueous extracts were then dissolved in methanol/chloroform and added to the polymer solution for the electrospinning process. The solution was placed in a 1 mL plastic syringe, fitted with a needle (21 G) and was put in the electrospinner. PCL nanofibers were produced by electrospinning using 12 kV in a high voltage power supplier. The fibers were collected on a flat surface located 12 cm from the charged needle tip. A syringe pump was used to inject the polymer flow in the system with the rate of 1mL/hr (EKC).
2.9. Fiber Antibacterial Activity
Certain weight (1mg) of fiber mats with different concentration of additives were tested for their antibacterial activity using disc diffusion assay discussed previously (section 2.3.). S. aureus ATCC25923 was prepared by diluting an overnight culture at 37 °C in MHB into fresh MHB to match the turbidity of a 0.5 McFarland standard, equivalent to 1.5 × CFU/mL. 1 mg of each electrospun fiber mat along with proper controls were cut using a scalpel blade and were placed on the MHA plates. After incubation for 24 hours at 37 °C, the results were obtained by investigating the diameter of the zone of inhibition for each sample.
3. Results and Discussion
3.1. Antibacterial Activity Screening by Disc Diffusion Assay
The antibacterial activities of the EtOAc and aqueous-extracted metabolites were evaluated using bacterial cultures on agar plates. As previously stated, the selection of bacterial strains was guided by statistical insights from existing literature. In this context,
S. aureus was chosen due to its prevalence on wound surfaces. Furthermore, to evaluate the efficiency of the extracted metabolites against antimicrobial-resistant bacteria, a strain of MRSA were included in the assessment to be tested against the most promising sample. Notably, a number of the samples exhibited substantial antibacterial activity against the chosen bacteria, indicating their potential as effective antimicrobial agents. The average inhibition zone and activity of each sample against
S. aureus ATCC25923 and MRSA M180920 can be observed in the following
Figure 1 and
Figure 2.
Screening tests against S. aureus ATCC25923 indicated that the EtOAc-extracted metabolites obtained from EL19 and EMSF 2-2, showed the highest antibacterial activity with inhibition zone of 11, and 7.2 mm, respectively. Given that EL19 demonstrated the highest activity against Gram-positive strains, it was subjected to additional screening against a distinct strain of MRSA. EL19 extracts exhibited significant antimicrobial activity against MRSA M180920 (with the average inhibition zone of 6.5 mm). This outcome underscores its potential as promising agents in combatting antimicrobial resistance.
After the visual inspection, the diameter of the inhibition zone was measured, which can be seen in the following
Table 1 and
Table 2.
As stated previously, the most active sample (EL19) was tested against MRSA M180920 for evaluation against antimicrobial resistant bacteria.
As it can be observed from the test results, the EtOAc-extracted metabolites was proved to be more effective in comparison to aqueous crude extracted metabolites suggesting that the active compounds produced by the endophytic fungi are highly polar in nature, which makes them less soluble in the organic solvent.
Furthermore, it's noteworthy that the screening process is normally labour and time-intensive and needs to be quantified and confirmed with supplementary experiments such as MIC. The interruption in inhibition zone does not necessarily mean the compound was inactive, especially if the active compounds are less polar, which diffuse more slowly into the culture medium [
25]. There is a similar result for EMSF1-1 against
S. aureus ATCC25923, which is demonstrated with a growth ring in the middle of the inhibition zone. This observation could potentially be attributed to variations in the polarity of different active compounds. This polarity difference might lead to the formation of a growth ring where activity still extends further. However, there is a need for isolation of the individual compounds to reach a better understanding of active compounds.
3.2. Determination of MIC values
The minimum inhibitory concentration (MIC) of the EtOAc extracts of active samples was measured, which has been demonstrated in
Table 3 and
Table 4. The results indicate that the most active sample against
S. aureus ATCC 25923 was EtOAc extracts obtained from EL 19 with the MIC level of 78.1 µg/ml.
EtOAc extracts obtained from EL 19 as the most active sample against
S. aureus was chosen for further testing against MRSA M180920. The results indicated that the MIC level for EtOAc extracts of EL 19 will remain the same against the chosen antimicrobial resistant
S. aureus, as it can be observed in
Table 4.
These findings have provided a deeper insight into the extracted secondary metabolites originated from EL 19, showcasing their effectiveness against bacteria in terms of quantity, which helps conservation of the product and avoids non-targeted specific toxicity. Furthermore, it would also give an opportunity to understand its viability compared with the commercial antibacterial agents [
26].
Given the previous classification of antibacterial activity by Famuyide et al., as good (MIC < 0.1 mg/mL), moderate (0.1 mg/mL ≤ MIC ≤ 0.625 mg/mL), and weak (MIC > 0.625 mg/mL) [
27], the antibacterial activity of EtOAc extracts of EL 19 with the MIC values of 78.1 µg/mL was displayed as good against
S. aureus ATCC 25923 and MRSA M180920. Besides, EtOAc extracts of EMSF 2-2 and EMSF 1-2 demonstrated a good activity against
S. aureus ATCC 25923. There are a few studies showing similar results for EtOAc extracted metabolites. For example, Phongpaichit et al. isolated
Botryosphaeria sp. and
Phomopsis sp. from
Garcinia species. The EtOAc metabolite extracts of these two isolates displayed a good antibacterial activity against
S. aureus and MRSA with the MIC values of 32 and 64 µg/mL, respectively [
28]. In another study Mishra et al. investigated the EtOAc extracts of
Aspergillus clavatonanicus strain MJ31 from
Mirabilis jalapa L. The results indicated an MIC value of 312 µg/mL against
S. aureus [
29], as was similar to the case for EMSF EtOAc extracts.
3.3. Determination of MBC values
After observing the turbidity caused by the existing strains of bacteria for each one of the MIC wells, The minimum bactericidal concentration of EL19 extracts was chosen to be investigated.
Table 5. demonstrates the results for bactericidal activity.
As it can be seen in the table. While the MIC level for EL 19 EtOAc extracts were the same for the chosen strains of bacteria, the MBC values was demonstrated to be different. The MBC values for S. aureus ATCC25923 was lower than the MBC values for MRSA M180920.
3.4. Identification of active sources by ITS sequencing
DNA sequencing of the ITS region was performed for a better understanding of the source plants. The target region for EL19, EL24, EMSF2-2, EN1, EK2, and EK3 was successfully amplified and resulted in the following
Table 6.
The identification of the active samples was achieved by comparing the existing sequence data that was available in the GenBank database. Results indicated that both EMSF 1-2 and EMSF 2-2 were identified as Alternaria species, EL 19 as Chaetomium species, and EK 3 as coniochaeta species. However, EK 3 exhibited a higher E-value, suggesting the presence of contaminants in the extracted DNA sample, impacting the precision of DNA quantification. Alternatively, EK3 might represent a potentially new species not previously documented.
Chaetomium species have demonstrated significant antimicrobial activity in previous literature. As an example, in a study conducted by Wang et al., the
Chaetomium globosum endophytic fungi was evaluated for its potential antibacterial effects against
S. aureus. The outcomes of this study revealed that GCP, a polysaccharide produced by the mentioned fungi, exhibited the MIC of 0.67 mg/mL. Furthermore, GCP demonstrated antibacterial properties by disrupting the inner membrane and enhancing cell permeability, while having no impact on the cell wall. This suggests its considerable potential for application in the pharmaceutical industry [
30].
Alternaria species have also demonstrated a notable antibacterial activity in previous literature. Endophytic fungi within this genus have been frequently isolated as endophytes from various plants. A comprehensive study in this regard is the work conducted by Tsyganenko et al., which investigated the biological activity of
Alternaria Species. The study identified and scrutinized the biological activity of various
Alternaria species. The results indicated that the secondary metabolites extracted from four different sources of
Alternaria species exhibited activity against
S. aureus [
31].
In a separate investigation conducted by Al Mousa et al., the antimicrobial potential of the endophytic fungi
Alternaria tenuissima and
Alternaria alternata, isolated from
Artemisia judaica L., was examined. EtOAc extracts from these fungi were subjected to testing against a range of Gram-positive and Gram-negative bacteria to assess their antibacterial activity. The outcomes demonstrated that both
Alternaria species exhibited an inhibition zone ranging between 25 to 30 mm against
S. aureus ATCC6538P [
32].
Lastly,
Coniochaeta species have exhibited antibacterial activity against Gram-positive bacteria. For example, the study conducted by Han et al. provides insight into this aspect. In their research, several compounds were isolated and identified from the fungus
Coniochaeta cephalothecoides. The findings revealed that the compound conipyridoins E displayed the strongest activity against the growth of both
S. aureus and MRSA, with a MIC value of 0.97 µM [
33].
3.5. Antibiofilm characteristics
The antibiofilm activity of the EtOAc extracts of EL 19, as the most active sample, was evaluated against the two strains of
S. aureus. The focus was on assessing the ability to inhibit the initial attachment of bacterial cells to polystyrene surfaces. Three distinct concentrations of extracts were examined (
× MIC,
× MIC, and
× MIC). Given that TSBG was used for the biofilm assays, the extract concentrations were adjusted based on the MIC values obtained using this medium. The study demonstrated that EL 19 extracts significantly inhibited bacterial cell attachment and, to some extent, reduced the biofilm formation at most concentrations tested. For MRSA M180920, reductions in biofilm biomass were observed to be ranging from 41% to 55%, when tested at
× MIC. At the same concentration, EL 19 demonstrated biofilm inhibition ranging from 47% to 59% in
S.
aureus ATCC25923, suggesting a slightly higher effectivity against
S.
aureus at this concentration. Similar trends were observed at the concentration of
× MIC, with higher biofilm inhibition against
S.
aureus ATCC25923 (ranging from 44% to 57%) compared to MRSA M180920 (ranging from 29% to 36%). At the concentration of
× MIC, the biofilm inhibition in MRSA M180920 and
S.
aureus ATCC25923 were comparable, ranging from 8% to 25% and 5% to 28%, respectively. The biofilm inhibition for each bacteria can be observed in
Figure 3.
Biofilms represent aggregates of single or multiple species of bacteria enveloped in a matrix consisting of polysaccharides, proteins, and DNA. This matrix serves as a protective housing that shields the bacteria from various environmental pressures. Beyond the physical barrier provided by the polymeric matrix, bacteria within a biofilm undergo transcriptional changes. This adaptive response allows them to react to perceived stressors and invoke resistance mechanisms, thereby protecting the cells from antibiotics and other antimicrobial threats [
34,
35]. The formation of biofilms serves as a survival strategy for bacteria to adapt to their living environment, particularly in challenging conditions [
36]. Within the protective shelter of a biofilm, microbial cells increase their tolerance and resistance to antibiotics and immune responses, causing challenges for the clinical treatment of biofilm infections. Both clinical and laboratory investigations have highlighted a clear correlation between biofilm infections and medical foreign bodies or indwelling devices [
37,
38]. Clinical observations and experimental studies have demonstrated that using antibiotics alone is not sufficient for eradicating biofilm formations [
38]. Furthermore, antimicrobial resistance reduces the efficiency of previously used antibiotics and intensifies the problem. Consequently, the effective treatment of biofilm infections using currently available antimicrobial agents has become crucial and urgent for clinicians. Given the recognition of
S. aureus as a prominent wound surface bacteria and a major biofilm-forming pathogen [
8,
39], in this study, EtOAc extracts of
Chaetomium globosum as the most active sample, were assessed against two strains of
S. aureus. As observed in the results, both bacterial strains were significantly impacted by the chosen extract, resulting in a strong antibiofilm inhibition Comparing these outcomes with previous literature, it is noteworthy that the ethyl acetate (EtOAc) extracts of the endophytic fungus
Aspergillus, for example, demonstrated an 80% reduction in biofilm formation of
S. aureus NRRL B-767 but at a concentration of 500 µg/mL [
40]. However, the range of the concentration for similar biofilm inhibition in EtOAc extracts of
Chaetomium globosum was recorded to be around 39 µg/mL. This extract was able to inhibit the biofilm formation of both bacteria. This aligns with findings from a prior study, such as the one conducted by Jalil et al. (2021) [
41], which revealed that an EtOAc extract of the endophytic fungus
Lasiodiplodia pseudotheobromae possessed antibiofilm activity against MRSA ATCC33591 at concentrations > 100 µg/mL but stimulated biofilm production at concentrations between 10 and 60 µg/mL. Thus, it is noteworthy that the reduction in biofilm formation by EtOAc extracts of
Chaetomium globosum was around 39 µg/mL.
3.6. PCL Fibers Antibacterial Activity
The early qualitative set up for checking antimicrobial activity of the produced fibers was performed using disc diffusion tests. The disc diffusion assays for the fibers containing different concentrations of EL19 were tested against
S. aureus ATCC25923 resulted in the inhibition zones demonstrated in
Figure 4 and
Table 7. The inhibition zone for tested samples for PCL fibers mixed with EL19 with the concentration of 3.716 mg/mL and 1.89 mg/mL was 1.4 mm and 0.95mm, respectively. The results indicated that the fiber mats successfully released their antibacterial additives on the MHA plates. Moreover, increasing the concentration of the additives increases the average inhibition diameter of the produced fibers.
In the initial phase of assessing the activity of the antibacterial agents within the application area,
In Vitro studies on the fiber mats were conducted using a disc diffusion assay. These studies not only confirmed the presence of antibacterial additives but also demonstrated successful release in the application area. Similar investigations have been undertaken to evaluate the antimicrobial activity of additives in PCL fibers. For example, in a study by Adeli-Sardou et al. [
42], the
In Vitro antibacterial activity of electrospun PCL/gelatin/Lawsone nanofiber scaffolds was tested using a disc diffusion assay. The findings indicated that the antibacterial activity of the mats increased with the rising concentration of lawsone. Specifically, PCL/GEL/lawsone 10% exhibited inhibition of the growth of
S. aureus, aligning with the outcomes observed in the present study.
5. Conclusions
In summary, this study explored the potential of 32 endophytic fungi isolated from 13 distinct indigenous Australian plants to inhibit the growth of S. aureus and MRSA as well as their capacity to inhibit biofilm formation. Initial antibacterial testing using a disc diffusion assay against S. aureus ATCC25923 for both aqueous and EtOAc extracts confirmed the activity of EtOAc extracts of EL 19, EMSF 1-2, EMSF 2-2, and EK 3 against the selected bacteria. Further quantitative evaluation through MIC tests identified EtOAc extracts of EL 19 as the most active sample with an MIC level of 78.1 µg/mL, which remained consistent against antimicrobial-resistant MRSA strains. DNA extraction revealed the active samples as Chaetomium globosum (EL 19), Alternaria sp. (EMSF 1-2 and EMSF 2-2), and Coniochaeta sp. (EK 3), with an interestingly higher E-value for EK 3 (3e-50 ), suggesting potential contamination or the presence of a yet-unrecorded species.
Continuing with EL 19, subsequent testing recorded an MBC level of 156 µg/mL for S. aureus ATCC25923 and 625 µg/mL against MRSA M180920. EL 19 EtOAc extract exhibited significant antibiofilm activity, reducing biofilm formation on polystyrene and preventing cell attachment, with the most substantial reduction observed in S. aureus ATCC25923 at × MIC (55% reduction). In the final step, the chosen extract was incorporated as an antibacterial additive in PCL electrospun fibers, and In Vitro testing using a disc diffusion assay against S. aureus ATCC25923 indicated an increasing inhibition zone with higher concentrations of additives in the produced fiber mats. This suggests a strong potential for the secondary metabolites of endophytes to be employed in electrospun fibers for wound dressing applications.
Author Contributions
Conceptualization, M.F., E.A.P., P.K., and B.Z.; methodology, M.F., E.A.P., P.K., and B.Z.; validation, M.F., E.A.P., P.K., and B.Z.; formal analysis, M.F.; investigation, M.F.; resources, M.F., E.A.P., P.K., and B.Z.; data curation, M.F., E.A.P., P.K., and B.Z.; writing—original draft preparation, M.F.; writing—review and editing, M.F., E.A.P., P.K., and B.Z.; visualization, M.F., E.A.P., P.K., and B.Z.; supervision, E.A.P., P.K, and B.Z.; project administration, M.F. and B.Z. All authors have read and agreed to the published version of the manuscript.
Funding
This research received no external funding.
Acknowledgments
The authors express their gratitude to the following individuals for their expertise and assistance at various stages of our study: Declan Watts, Daniel J. Caruso, and Rebecca Alfred, from Swinburne University of Technology. Additionally, we extend our thanks to Swinburne University of Technology for its support.
Conflicts of Interest
The authors declare no conflict of interest.
References
- Mirhaj, M., S. Labbaf, M. Tavakoli, and A.M. Seifalian, Emerging treatment strategies in wound care. International Wound Journal, 2022, 19, 1934–1954. [CrossRef]
- Yao, G., X. Mo, C. Yin, W. Lou, Q. Wang, S. Huang, L. Mao, S. Chen, K. Zhao, T. Pan, et al., A programmable and skin temperature–activated electromechanical synergistic dressing for effective wound healing. Science Advances, 2022, 8, eabl8379. [CrossRef] [PubMed]
- Firoozbahr, M., P. Kingshott, E.A. Palombo, and B. Zaferanloo, Recent Advances in Using Natural Antibacterial Additives in Bioactive Wound Dressings. Pharmaceutics, 2023, 15, 644. [CrossRef]
- Aderibigbe, B.A., Chapter 6 - Efficacy of Polymer-Based Wound Dressings in Chronic Wounds, in Modeling and Control of Drug Delivery Systems, A.T. Azar, Editor. 2021, Academic Press. p. 79-110.
- Unalan, I., B. Slavik, A. Buettner, W.H. Goldmann, G. Frank, and A.R. Boccaccini, Physical and Antibacterial Properties of Peppermint Essential Oil Loaded Poly (ε-caprolactone) (PCL) Electrospun Fiber Mats for Wound Healing. Frontiers in Bioengineering and Biotechnology 2019, 7. [CrossRef]
- Guglielmi, P., V. Pontecorvi, and G. Rotondi, Natural compounds and extracts as novel antimicrobial agents. Expert Opinion on Therapeutic Patents, 2020, 30, 949–962. [CrossRef] [PubMed]
- García-Salinas, S., M. Evangelopoulos, E. Gámez-Herrera, M. Arruebo, S. Irusta, F. Taraballi, G. Mendoza, and E. Tasciotti, Electrospun anti-inflammatory patch loaded with essential oils for wound healing. Journal of Pharmaceutics, 2020, 577, 119067. [CrossRef]
- Alam, M.M., M.N. Islam, M.D. Hossain Hawlader, S. Ahmed, A. Wahab, M. Islam, K.M.R. Uddin, and A. Hossain, Prevalence of multidrug resistance bacterial isolates from infected wound patients in Dhaka, Bangladesh: A cross-sectional study. International Journal of Surgery Open, 2021, 28, 56–62. [CrossRef]
- Köck, R. Köck, R., K. Becker, B. Cookson, J. van Gemert-Pijnen, S. Harbarth, J. Kluytmans, M. Mielke, G. Peters, R. Skov, and M. Struelens, Methicillin-resistant Staphylococcus aureus (MRSA): burden of disease and control challenges in Europe. Eurosurveillance, 2010, 15. [Google Scholar] [CrossRef]
- Caruso, D.J., E.A. Palombo, S.E. Moulton, P.J. Duggan, and B. Zaferanloo, Antibacterial and Antibiofilm Activity of Endophytic Alternaria sp. Isolated from Eremophila longifolia. Antibiotics, 2023, 12, 1459. [CrossRef]
- Watts, D., E.A. Palombo, A. Jaimes Castillo, and B. Zaferanloo, Endophytes in Agriculture: Potential to Improve Yields and Tolerances of Agricultural Crops. Microorganisms, 2023, 11, 1276. [CrossRef]
- Caruso, D.J., E.A. Palombo, S.E. Moulton, and B. Zaferanloo, Exploring the promise of endophytic fungi: a review of novel antimicrobial compounds. Microorganisms, 2022, 10, 1990. [CrossRef]
- Pennacchio, M., A.S. Kemp, R.P. Taylor, K.M. Wickens, and L. Kienow, Interesting biological activities from plants traditionally used by Native Australians. Journal of Ethnopharmacology, 2005, 96, 597–601. [CrossRef]
- Clarke, P., ABORIGINAL USE OF SUBTERRANEAN PLANT PARTS IN SOUTHERN SOUTH AUSTRALIA. Records of the South Australian Museum, 1988.
- Kaewkla, O. and C.M.M. Franco, Rational Approaches to Improving the Isolation of Endophytic Actinobacteria from Australian Native Trees. Microbial Ecology, 2013, 65, 384–393. [CrossRef]
- Wang, B., M.J. Priest, A. Davidson, C.L. Brubaker, M.J. Woods, and J.J. Burdon, Fungal endophytes of native Gossypium species in Australia. Mycological Research, 2007, 111, 347–354. [CrossRef]
- ngrey, S.D., L.A. Pearson, J.A. Kalaitzis, and B.A. Neilan, Australian bush medicines harbour diverse microbial endophytes with broad-spectrum antibacterial activity. Journal of Applied Microbiology, 2021, 131, 2244–2256. [CrossRef]
- Strobel, G. and B. Daisy, Bioprospecting for microbial endophytes and their natural products. Microbiology and molecular biology reviews. MMBR, 2003, 67, 491–502. [CrossRef] [PubMed]
- Zaferanloo, B., T.D. Quang, S. Daumoo, M.M. Ghorbani, P.J. Mahon, and E.A. Palombo, Optimization of protease production by endophytic fungus, Alternaria alternata, isolated from an Australian native plant. World J Microbiol Biotechnol, 2014, 30, 1755–62. [CrossRef]
- Biswas, D., P. Biswas, S. Nandy, A. Mukherjee, D.K. Pandey, and A. Dey, Endophytes producing podophyllotoxin from Podophyllum sp. and other plants: A review on isolation, extraction and bottlenecks. South African Journal of Botany, 2020, 134, 303–313. [CrossRef]
- Antimicrobial susceptibility testing EUCAST disk diffusion method. European Society of Clinical Microbiology and Infectious Diseases (version 7.0), (January 2019) http://www.eucast.org/ast_of_bacteria/disk_diffusion_methodology/.
- EUCAST. Reading Guide for Broth Microdilution ver. 4.0. Available online:. https://www.eucast.org/fileadmin/src/media/PDFs/EUCAST_files/Disk_test_documents/2022_manuals/R
eading_guide_BMD_v_4.0_2022.pdf.
- STEPANOVIĆ, S., D. VUKOVIĆ, V. HOLA, G.D. BONAVENTURA, S. DJUKIĆ, I. ĆIRKOVIĆ, and F. RUZICKA, Quantification of biofilm in microtiter plates: overview of testing conditions and practical recommendations for assessment of biofilm production by staphylococci. APMIS, 2007, 115, 891–899. [CrossRef]
- Jadhav, S., R. Shah, M. Bhave, and E.A. Palombo, Inhibitory activity of yarrow essential oil on Listeria planktonic cells and biofilms. Food Control, 2013, 29, 125–130. [CrossRef]
- Klančnik, A., S. Piskernik, B. Jeršek, and S.S. Možina, Evaluation of diffusion and dilution methods to determine the antibacterial activity of plant extracts. Journal of Microbiological Methods, 2010, 81, 121–126. [CrossRef] [PubMed]
- Andrews, J.M., Determination of minimum inhibitory concentrations. Journal of antimicrobial Chemotherapy, 2001. 48(suppl_1): p. 5-16.
- Famuyide, I.M., A.O. Aro, F.O. Fasina, J.N. Eloff, and L.J. McGaw, Antibacterial and antibiofilm activity of acetone leaf extracts of nine under-investigated south African Eugenia and Syzygium (Myrtaceae) species and their selectivity indices. BMC Complementary and Alternative Medicine, 2019, 19, 141. [CrossRef]
- Phongpaichit, S., N. Rungjindamai, V. Rukachaisirikul, and J. Sakayaroj, Antimicrobial activity in cultures of endophytic fungi isolated from Garcinia species. FEMS Immunology & Medical Microbiology, 2006, 48, 367–372. [CrossRef]
- Mishra, V.K., A.K. Passari, P. Chandra, V.V. Leo, B. Kumar, S. Uthandi, S. Thankappan, V.K. Gupta, and B.P. Singh, Determination and production of antimicrobial compounds by Aspergillus clavatonanicus strain MJ31, an endophytic fungus from Mirabilis jalapa L. using UPLC-ESI-MS/MS and TD-GC-MS analysis. PLoS One, 2017, 12, e0186234. [CrossRef]
- Wang, Z., R. Xue, J. Cui, J. Wang, W. Fan, H. Zhang, and X. Zhan, Antibacterial activity of a polysaccharide produced from Chaetomium globosum CGMCC 6882. International Journal of Biological Macromolecules, 2019, 125, 376–382. [CrossRef] [PubMed]
- syganenko, K., Y.I. Savchuk, L. Nakonechna, and I. Kurchenko, The biological activity of Alternaria species. Мікрoбіoлoгічний журнал, 2018(80,№ 4): p. 78-87.
- Mousa, A.A.A., H. Mohamed, A.M.A. Hassane, and N.F. Abo-Dahab, Antimicrobial and cytotoxic potential of an endophytic fungus Alternaria tenuissima AUMC14342 isolated from Artemisia judaica L. growing in Saudi Arabia. Journal of King Saud University - Science, 2021, 33, 101462. [CrossRef]
- Han, J., C. Liu, L. Li, H. Zhou, L. Liu, L. Bao, Q. Chen, F. Song, L. Zhang, E. Li, et al., Decalin-Containing Tetramic Acids and 4-Hydroxy-2-pyridones with Antimicrobial and Cytotoxic Activity from the Fungus Coniochaeta cephalothecoides Collected in Tibetan Plateau (Medog). The Journal of Organic Chemistry, 2017, 82, 11474–11486. [CrossRef]
- Haney, E.F., M.J. Trimble, J.T. Cheng, Q. Vallé, and R.E.W. Hancock, Critical Assessment of Methods to Quantify Biofilm Growth and Evaluate Antibiofilm Activity of Host Defence Peptides. Biomolecules, 2018, 8, 29. [CrossRef]
- Haney, E.F., M.J. Trimble, and R.E.W. Hancock, Microtiter plate assays to assess antibiofilm activity against bacteria. Nature Protocols, 2021, 16, 2615–2632. [CrossRef]
- De la Fuente-Núñez, C., F. Reffuveille, L. Fernández, and R.E. Hancock, Bacterial biofilm development as a multicellular adaptation: antibiotic resistance and new therapeutic strategies. Current opinion in microbiology, 2013, 16, 580–589. [CrossRef]
- Hall-Stoodley, L., J.W. Costerton, and P. Stoodley, Bacterial biofilms: from the Natural environment to infectious diseases. Nature Reviews Microbiology, 2004, 2, 95–108. [CrossRef]
- Wu, H., C. Moser, H.-Z. Wang, N. Høiby, and Z.-J. Song, Strategies for combating bacterial biofilm infections. International Journal of Oral Science, 2015, 7, 1–7. [CrossRef] [PubMed]
- Archer, N.K., M.J. Mazaitis, J.W. Costerton, J.G. Leid, M.E. Powers, and M.E. Shirtliff, Staphylococcus aureus biofilms. Virulence, 2011, 2, 445–459. [CrossRef]
- Abdelgawad, M.A., A.A. Hamed, A.A. Nayl, M.S.E.M. Badawy, M.M. Ghoneim, A.M. Sayed, H.M. Hassan, and N.M. Gamaleldin, The Chemical Profiling, Docking Study, and Antimicrobial and Antibiofilm Activities of the Endophytic fungi Aspergillus sp. AP5. Molecules, 2022, 27, 1704. [CrossRef]
- Jalil, M.T.M. and D. Ibrahim, Fungal extract of Lasiodiplodia pseudotheobromae IBRL OS-64 inhibits the growth of skin pathogenic bacterium and attenuates biofilms of methicillin-resistant Staphylococcus aureus. MJMS, 2021, 28, 24. [CrossRef]
- Adeli-Sardou, M., M. Torkzadeh-Mahani, M.M. Yaghoobi, and M. Dodel, Antibacterial and Anti-biofilm Investigation of Electrospun PCL/gelatin/Lawsone Nano Fiber Scaffolds against Biofilm Producing Bacteria. Biomacromolecular Journal, 2018, 4, 46–57.
|
Disclaimer/Publisher’s Note: The statements, opinions and data contained in all publications are solely those of the individual author(s) and contributor(s) and not of MDPI and/or the editor(s). MDPI and/or the editor(s) disclaim responsibility for any injury to people or property resulting from any ideas, methods, instructions or products referred to in the content. |
© 2023 by the authors. Licensee MDPI, Basel, Switzerland. This article is an open access article distributed under the terms and conditions of the Creative Commons Attribution (CC BY) license (http://creativecommons.org/licenses/by/4.0/).